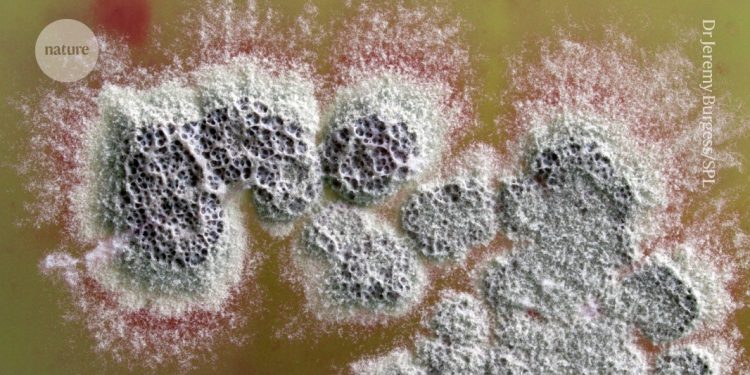
Nuevo antibiótico potente que puede matar superbacterias descubiertas en bacterias del suelo

una colonia de Streptomyces coelicolor Las bacterias secretan un compuesto antibiótico (rojo) al medio circundante.Crédito: Dr. Jeremy Burgess/Biblioteca de fotografías científicas
Al estudiar el proceso mediante el cual una bacteria del suelo produce naturalmente un medicamento conocido, los científicos han descubierto un poderoso antibiótico que podría ayudar a combatir infecciones resistentes a los medicamentos.
En los experimentos descritos en el Revista de la Sociedad Química Estadounidense los lunes1el equipo estudió la vía de varios pasos que sigue la bacteria Streptomyces coelicolor utiliza para producir el antibiótico metilenomicina A, que se identificó por primera vez en 19652,3. Descubrieron un compuesto intermedio, llamado premetilenomicina C lactona, cuya actividad antimicrobiana era 100 veces más fuerte que la del producto final. Pequeñas dosis mataron cepas de bacterias que se sabe que causan infecciones difíciles de tratar.
Cinco formas en que la ciencia está abordando la crisis de resistencia a los antibióticos
El descubrimiento fue una «sorpresa», dice el coautor del estudio Gregory Challis, biólogo químico de la Universidad de Warwick en Coventry, Reino Unido. «Como seres humanos, anticipamos que la evolución perfecciona el producto final, por lo que se esperaría que la molécula final fuera el mejor antibiótico y que los intermedios fueran menos potentes», afirma. Pero el hallazgo «es un gran ejemplo de lo que es la evolución de un 'relojero ciego'. Y es una buena manera de ejemplificarlo de una manera muy molecular», añade Challis.
Resistencia a los antimicrobianos es una amenaza creciente, que se prevé que cause 39 millones de muertes en todo el mundo durante los próximos 25 años. Los investigadores dicen que el descubrimiento de un potente compuesto antimicrobiano podría conducir a nuevos medicamentos para combatir la resistencia.
El trabajo subraya «el potencial de tales estudios para identificar nuevos andamios químicos bioactivos a partir de vías 'antiguas'», dice Gerard Wright, bioquímico de la Universidad McMaster en Hamilton, Canadá.
Descubrimiento accidental
En 2006, Challis y sus colegas comenzaron a estudiar la vía molecular a través de la cual Streptomyces coelicolor produce metilenomicina A. Para ello, eliminaron uno a uno los genes que codifican las enzimas implicadas en cada paso. Su trabajo se basó en esfuerzos anteriores realizados en 2002 para secuenciar el genoma de la bacteria.4.
Nuevo antibiótico que mata bacterias resistentes a los medicamentos descubierto en el jardín de un técnico
En 2010, el equipo había mapeado el mecanismo que utilizaba la bacteria para producir metilenomicina A e identificó varias moléculas intermedias que producía a lo largo del camino.
«Simplemente estábamos haciendo una investigación muy fundamental sobre el cielo azul», dice Challis. «Descubrimos estos intermediarios y los dejamos por un tiempo porque no sabíamos muy bien qué hacer con ellos».
Varios años después, alrededor de 2017, un estudiante de doctorado en el laboratorio de Challis probó la actividad antimicrobiana de estas moléculas intermedias.
Estas pruebas revelaron que dos moléculas, incluida la lactona de premetilenomicina C, eran mucho más efectivas que la metilenomicina A para atacar siete cepas de bacterias grampositivas, incluidas Estafilococo aureusque infecta la piel, la sangre y los órganos internos, y enterococo faeciumque puede causar infecciones mortales en el torrente sanguíneo y urinarias.
La concentración más baja de lactona de premetilenomicina C necesaria para matar cepas de virus resistentes a los medicamentos. Estafilococo aureus era sólo 1 microgramo por mililitro, en comparación con los 256 microgramos por mililitro de metilenomicina A. El compuesto también podría matar bacterias en dosis mucho más pequeñas que las necesarias para la vancomicina, un antibiótico de «última línea» utilizado para tratar infecciones causadas por dos enterococo faecium cepas, para que sea eficaz.